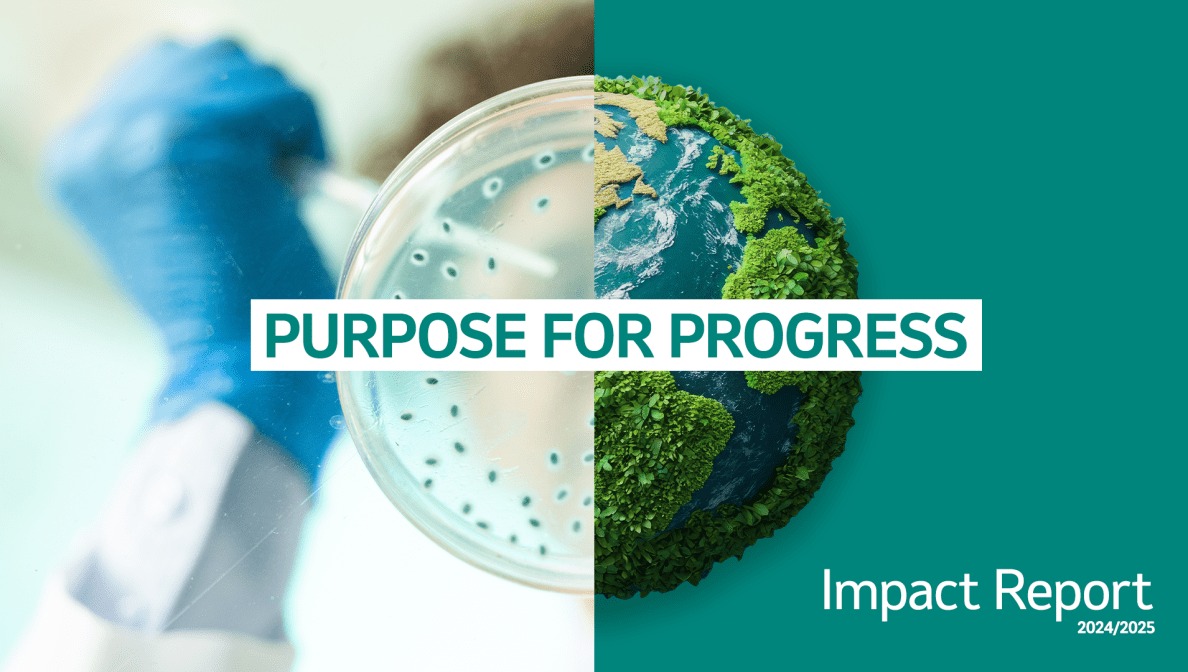

MSD publishes Purpose for Progress Impact Report 2024/2025
August 29, 2025
Our company’s purpose is to use the power of leading-edge science to save and improve lives around the world. This purpose serves as our compass and guides us every day. Our Purpose for Progress: MSD 2024/2025 Impact Report provides a comprehensive view of how we’re pursuing innovative science for the health of people and animals and ensuring our efforts drive significant and sustainable value.
“Our long-standing commitment and focus on advancing access to health, operating responsibly and implementing strategies that protect the health of people, animals and the planet is unwavering,” said Rob Davis, chairman and CEO. “As we continue to navigate the rapid pace of change happening all around us, I am proud of the progress we’ve made thus far, and I remain optimistic about our future.”
A few highlights from this year’s report*
*All numbers as of 2024 (report page 15)
Our employees worldwide played a pivotal role in delivering novel solutions that addressed some of the world’s most serious and complex global health challenges. We’re proud that in 2024, our medicines and vaccines reached more than 450 million people around the world.
- Access to health: In collaboration with global health stakeholders, our social investments aim to advance access to quality health systems, and we seek to ensure that our products are accessible and affordable worldwide.
- Employees: We recognize that our ability to excel depends on the integrity, knowledge, imagination, skill, diversity of thought, perspectives and experiences, and well-being of our employees.
- Environmental sustainability: We strive to operate our business sustainably, considering the impact on both the health of our planet and its inhabitants, while also providing opportunities for product innovation and reduction in costs and risks. We have a long history of environmental stewardship and compliance, and we continuously evolve our strategy and efforts in the face of a changing climate.
- Ethics and values: Our ethics and values are at the center of everything we do. Through our unwavering commitment to transparency, we are committed to earning the trust and confidence of our stakeholders.
Learn more about our progress in these areas and read this year’s report.